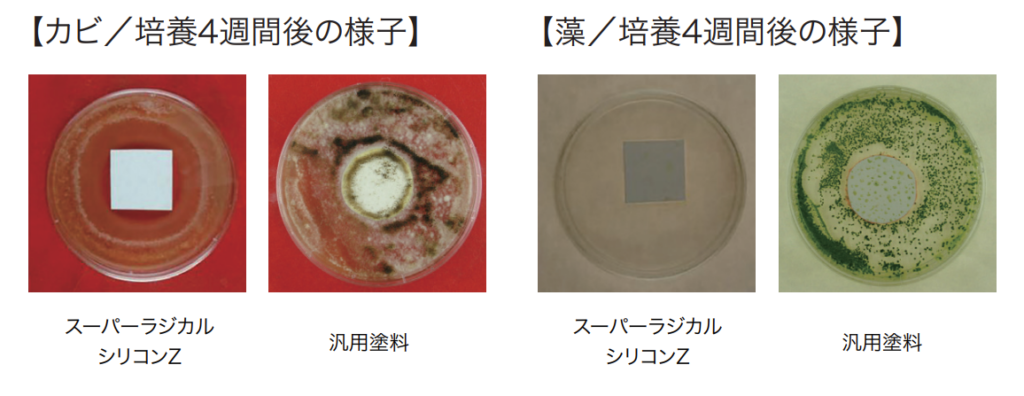

スーパーラジカルシリコンZとは?新発売シリコン塗料の特徴と性能を徹底解説


アステックペイントが販売するスーパーラジカルシリコンZは、「塗り替えのコストを抑えたい。でも性能面で妥協はしたくない」そのようなご要望にお応えするための商品高機能型シリコン系塗料です。今回の記事では「スーパーラジカルシリコンZ」の性能と特徴を分かりやすく徹底解説します。
目次
高耐候シリコン「スーパーラジカルシリコンZ」の特徴
スーパーラジカルシリコンZは、水性形一液外壁用シリコン系上塗材で、期待耐用年数は10~12年という高い耐候性を持っています。価格を抑えつつも、他社メーカーの汎用シリコン塗料と遜色のない、もしくはそれ以上の性能を実現しています。

ラジカル制御技術による高い耐候性
スーパーラジカルシリコンZの特徴として、塗膜の劣化を抑制する「ラジカル制御技術」があります。
【ラジカルとは?】
ラジカルとは、塗料に色を付ける顔料の主成分である「酸化チタン」が、紫外線の影響を受けることで発生する劣化因子です。このラジカルが発生すると、樹脂の結合が破壊され、塗膜の劣化が進行してしまいます。

【ラジカル制御メカニズム】
スーパーラジカルシリコンZは、ラジカル制御型白色顔料を採用しています。このラジカル制御型白色顔料は、ラジカルが発⽣しにくく、またラジカルが発⽣した場合にも、シールド層がラジカルの放出を防ぐため、塗膜の劣化を抑制します。

製品特徴①高耐候性

促進耐候性試験(キセノンランプ式)において、約10~12年相当(期待耐用年数)経過後も光沢保持率80%以上を保持しています。ラジカル制御技術により、塗膜の劣化要因であるラジカルの発生を抑制し、塗膜が劣化しにくいため建物を長期間保護します。
製品特徴②低汚染性

一般的なシリコン塗料に使用されているアクリルシリコン樹脂は表層の柔軟性が高く、汚れが付着しやすくなっております。しかし、柔軟性のある層を強靭な層でコーティングすることにより塗膜に汚れが付着するのを防ぎ、建物の美観を保持しています。
一般的なシリコン塗料に使用されているアクリルシリコン樹脂は表層の柔軟性が高く、汚れが付着しやすくなっております。しかし、柔軟性のある層を強靭な層でコーティングすることにより塗膜に汚れが付着するのを防ぎ、建物の美観を保持しています。
■雨筋暴露試験 (3ヶ月経過)

雨筋ばく露試験では、他社水性低汚染塗料と同等の優れた低汚染性能を示しました。
製品特徴③可とう性
■JISA6909 可とう性試験

可とう性の低い塗膜は、建物の動きによりひび割れを起こすリスクがあります。スーパーラジカルシリコンZは、上述のコア・シェル構造により、外部からの力を弾力性のあるコア層が吸収するため、下地の動きに追従し、ひび割れしにくくなっています。JIS A 6909の可とう性試験では、90°以上折り曲げても塗膜にひび割れが発生しない結果を示しました。
製品特徴④防カビ・防藻性
■「JIS Z 2911 かび抵抗性試験⽅法」「藻抵抗性試験(社内試験方法)」(4週間経過)
「JIS Z 2911 かび抵抗性試験⽅法」および「藻抵抗性試験(社内試験方法)」に合格しています。カビや藻の発生を抑制し、美観の維持に貢献します。
オプションで「アステックプラスSW」を添加し防カビ・防藻性をさらに強化することも可能です。
製品データ・対応素材
| 項目 | 詳細 |
| 適応下地 | ・窯業系サイディング ・モルタル ・ALC ・コンクリート ・波型スレート(外壁) ※各種旧塗膜 |
| 適応下塗材 | ・ホワイトフィラーAⅡ ・エピテックフィラーAEⅡ ・エポパワーシーラー ・エポパワーシーラー-JY ・弾性エポシーラー ・エポプレミアムシーラープライマー-JY ・エクセルエポシーラー ・プレミアムSSシーラープライマー ・サーモテックシーラー ・リベット ・ミッチャクロンマルチ |
工程 | 上塗 |
製品名 | スーパーラジカルシリコンZ |
荷姿 | 15㎏ |
| 希釈 | ローラー:0~5% エアレス:0~10% |
| 塗布量 | 0.25~0.35㎏/m2 |
| 塗回数 | 2 |
| 工程内(25℃) | 2時間以上 |
| 工程間 | – |
| 最終養生 | 24時間以上 |
| 塗装法 | 刷毛/ローラー/エアレス |
下地調整方法・施工上の注意
スーパーラジカルシリコンZの塗装において、適切な下地調整が重要です。下塗材の使用については、それぞれの製品仕様書をご参照ください。
特に注意が必要な点としては、塗装後の補修や塗り替えです。
「スーパーラジカルシリコンZ」を塗装してから1ヶ月以内は、原則として弱溶剤塗料での塗り替えや補修は避けてください。
まとめ
今回は「スーパーラジカルシリコンZ」についてご紹介させていただきました。「低コスト」と「高機能性」を両立させたシリコン系塗料をお探しの方は、ぜひ「スーパーラジカルシリコンZ」をご検討ください。
塗装業における課題解決なら
お任せください
AP ONLINEを運営している(株)アステックペイントは、塗装会社様の様々な課題解決の支援をしています。どんな内容でも構いません。まずは一度現状のお悩みや要望をお聞かせください。
\例えば、こんなお悩みありませんか?/
- コストカットをはかりたい
- 元請け案件を増やしていきたいが、方法が分からない
- 案件数を増やしたいが、成約率が低い(営業力に課題がある)
- 競合他社との差別化に悩んでいる
- 売上、粗利を増やしたい
| お取引様の声・実績 |



この記事を読んだ人におすすめの記事
- おすすめの記事はまだありません。





